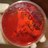

Activity-specific mobility of adults in a rural region of western Kenya

Zoonoses & EID @ZoonoticDisease
2086 days ago
Great to see: latest collab paper out today @thePeerJ
Activity-specific mobility of adults in a rural region of western Kenya https://t.co/7DOR0Zqg0X
@jessRfloyd @nruktanonchai @JosephOgola14
@AndyTatem @ericfevre N.Wardrop
@WorldPopProject
@ILRI @IGHLiverpool #globalhealth



Nick W Ruktanonchai @nruktanonchai
2086 days ago
 repost on X
repost on X